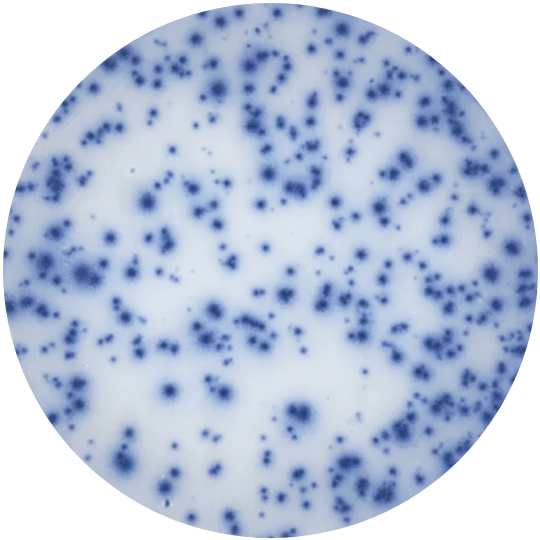

ELISPOT is the most sensitive technique available for the detection of immune cells which secrete specific signature proteins such as antibodies or cytokines. It is the state-of-the-art method for the detection, measurement and functional analysis of immune cells.
Visualize the Secretory Product of Individual Cells
ELISPOT assays measure the secretory activity of individual cells. The unique sensitivity of ELISPOT assays vs. supernatant-based measurements results from the fact that the analyte is captured directly around the secreting cell as it is being released, before it can be diluted in the supernatant, absorbed by receptors of adjacent cells, or degraded by proteases.
ELISPOT assays are also more sensitive for detecting rare cells than flow cytometry-based techniques. By measuring the frequencies of the antigen-specific cells and the types of molecules these lymphocytes secrete, ELISPOT assays establish both the magnitude (clonal size) and quality (effector class) of antigen-specific immunity.


Why ELISPOT?
-
Accurate ex vivo frequency measurements down to the one-in-1,000,000 cell range.
This resolution is orders of magnitude higher than what can be reached with intracellular cytokine or tetramer staining or by ELISA measurements. This added sensitivity is critical since antigen-specific T cells typically occur in low frequencies in vivo.
High-throughput T cell analysis becomes feasible. A trained team in a reference laboratory can test hundreds of samples for reactivity to dozens of antigens.
-
Fewer cells are required compared to other cellular assays.
For example, 45ml of blood is sufficient for testing reactivity to 600 different antigens/peptides. Determinants targeted by CD4 or CD8 cells can be defined. Because few cells are needed and the assay can be performed in high-throughput mode, our ELISPOT assays are ideal for screening peptide libraries for determinant mapping.
-
No Loss of Function
Cryopreserved human lymphocytes can be tested without loss of function. Pre- and post-treatment samples can be tested side-by-side and results can be reproduced.
CTL's founding scientists take pride in having established the technical and scientific foundations of cytokine ELISPOT analysis (see peer-reviewed publications listed by theme).
Why CTL?
At the very heart of science are exact, objective, and reproducible measurements. The precise evaluation of even such pristine ELISPOT results is impossible when the spots are counted visually.
By introducing and patenting ELISPOT image analysis, we converted the previously time-consuming and subjective evaluation of ELISPOT results into an automated and objective process.
- Which cytokine spots are produced by antigen-specific T cells (that are to be measured) vs. those produced by bystander cells—being of no T cell diagnostic value?
- What do small vs. big spots mean?
- Where should the cutoffs be set for minimal/maximal spot size when counting and analyzing the different cytokine ELISPOT results?
- Are measurements made at single-cell resolution?
- In what frequency range are accurate measurements made?
- If there are antagonistic cytokines produced simultaneously, to what extent do they interfere with the results?
- How many replicates are required to produce significant results?


We Orchestrate the Largest Concentrated Effort Around ELISPOT
Starting from its CWRU-based academic roots, CTL has grown to become the world leader in cytokine ELISPOT assay development, automated image analysis, and data management. Over fifty employees at CTL dedicate their full-time efforts specifically to the ELISPOT technology. These efforts are complemented by over 15 academic scientists at CWRU and by close collaboration with many scientists worldwide.
CTL has been selected as the only ELISPOT reference laboratory by the Cancer Vaccine Consortium (CVC). Dozens of the finest immunology laboratories have entered collaborations contributing invaluable expertise. This alliance constitutes the largest group in the world to further the frontiers of ELISPOT technologies.
The ImmunoSpot® Product Line has Emerged as the Crystallization of Science
We provide scientifically-validated ELISPOT analysis equipment, including three analyzer models to meet different user needs and budgets, satellites, accessory software, and data management solutions. In addition, CTL offers image analysis services, ELISPOT Hands-on Workshops, image analysis training, and complete Contract Research Services for clinical trials. Join the community of those who do not compromise in elevating ELISPOT to an exact science!
See how CTL continues to lead the ELISPOT field for over 20 years.
ELISPOT vs Other Applications
Differences between ELISPOT assays and other approaches for measuring antigen-specific T cell immunity.Every naïve T cell expresses a unique T cell receptor (TCR) which is specific for a single antigen. In order to recognize an infinite number of microbial antigens, T cells rely on an extensive diversity of TCRs (~1012 possible specificities). The frequencies of specific T cells are often very low, typically settling around 1:10,000 for effector memory or memory cells.
Therefore, techniques measuring T cell immunity need to be sensitive enough to detect these rare cells. ELISPOT assays measure the magnitude and quality of T cell immunity at single-cell resolution by detecting antigen-specific T cells that secrete cytokines and effector molecules like granzyme B and perforin.
ELISPOT Assays Visualize the Secretory Product of Individual Cells
ELISPOT assays measure the secretory activity of individual cells. The unique sensitivity of ELISPOT assays vs. supernatant-based measurements results from the fact that the analyte is captured directly around the secreting cell as it is being released, before it can be diluted in the supernatant, absorbed by receptors of adjacent cells, or degraded by proteases.
ELISPOT assays are also more sensitive for detecting rare cells than flow cytometry-based techniques. By measuring the frequencies of the antigen-specific cells and the types of molecules these lymphocytes secrete, ELISPOT assays establish both the magnitude (clonal size) and quality (effector class) of antigen-specific immunity.
[ Single Color Human T Cell ELISPOT Diagram]
Why ELISPOT
Accurate ex vivo frequency measurements down to the one-in-1,000,000 cell range.
This resolution is orders of magnitude higher than what can be reached with intracellular cytokine or tetramer staining or by ELISA measurements. This added sensitivity is critical since antigen-specific T cells typically occur in low frequencies in vivo.
High-throughput T cell analysis becomes feasible. A trained team in a reference laboratory can test hundreds of samples for reactivity to dozens of antigens.
Fewer cells are required compared to other cellular assays.
For example, 45ml of blood is sufficient for testing reactivity to 600 different antigens/peptides. Determinants targeted by CD4 or CD8 cells can be defined. Because few cells are needed and the assay can be performed in high-throughput mode, our ELISPOT assays are ideal for screening peptide libraries for determinant mapping.
No Loss of Function
Cryopreserved human lymphocytes can be tested without loss of function. Pre- and post-treatment samples can be tested side-by-side and results can be reproduced.
CTL's founding scientists take pride in having established the technical and scientific foundations of cytokine ELISPOT analysis (see peer-reviewed publications listed by theme).
We have elevated ELISPOT to an exact science, transforming it into the robust and validated T cell diagnostic tool it is today. We would like to share this expertise with you.
Interested in learning more about Why ELISPOT? Download our ImmunoSpot brochure.
[Single-color ELISPOT Well]
Why CTL
At the very heart of science are exact, objective, and reproducible measurements. The precise evaluation of even such pristine ELISPOT results is impossible when the spots are counted visually.
By introducing and patenting ELISPOT image analysis, we converted the previously time-consuming and subjective evaluation of ELISPOT results into an automated and objective process.
- Which cytokine spots are produced by antigen-specific T cells (that are to be measured) vs. those produced by bystander cells—being of no T cell diagnostic value?
- What do small vs. big spots mean?
- Where should the cutoffs be set for minimal/maximal spot size when counting and analyzing the different cytokine ELISPOT results?
- Are measurements made at single-cell resolution?
- In what frequency range are accurate measurements made?
- If there are antagonistic cytokines produced simultaneously, to what extent do they interfere with the results?
- How many replicates are required to produce significant results?
[Scientist Using CTL Analyzer]
We Orchestrate the Largest Concentrated Effort Around ELISPOT
Starting from its CWRU-based academic roots, CTL has grown to become the world leader in cytokine ELISPOT assay development, automated image analysis, and data management. Over fifty employees at CTL dedicate their full-time efforts specifically to the ELISPOT technology. These efforts are complemented by over 15 academic scientists at CWRU and by close collaboration with many scientists worldwide.
CTL has been selected as the only ELISPOT reference laboratory by the Cancer Vaccine Consortium (CVC). Dozens of the finest immunology laboratories have entered collaborations contributing invaluable expertise. This alliance constitutes the largest group in the world to further the frontiers of ELISPOT technologies.
The ImmunoSpot® Product Line has Emerged as the Crystallization of Science
We provide scientifically-validated ELISPOT analysis equipment, including three analyzer models to meet different user needs and budgets, satellites, accessory software, and data management solutions. In addition, CTL offers image analysis services, ELISPOT Hands-on Workshops, image analysis training, and complete Contract Research Services for clinical trials. Join the community of those who do not compromise in elevating ELISPOT to an exact science!
See how CTL continues to lead the ELISPOT field for over 20 years.
ELISPOT vs Other Applications
Differences between ELISPOT assays and other approaches for measuring antigen-specific T cell immunity.
Every naïve T cell expresses a unique T cell receptor (TCR) which is specific for a single antigen. In order to recognize an infinite number of microbial antigens, T cells rely on an extensive diversity of TCRs (~1012 possible specificities). The frequencies of specific T cells are often very low, typically settling around 1:10,000 for effector memory or memory cells.
Therefore, techniques measuring T cell immunity need to be sensitive enough to detect these rare cells. ELISPOT assays measure the magnitude and quality of T cell immunity at single-cell resolution by detecting antigen-specific T cells that secrete cytokines and effector molecules like granzyme B and perforin.